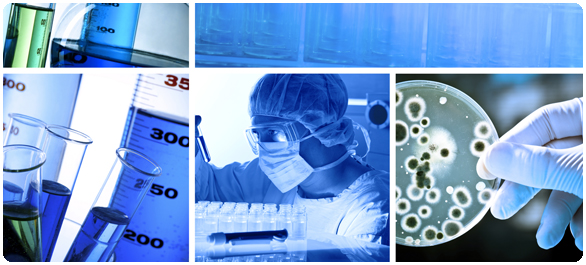
โคลิฟอร์มตัวก่อเชื้อ โคลิฟอร์มตัวก่อเชื้อ

on
โคลิฟอร์มตัวก่อเชื้อ (ตอนที่ 2 และตอนจบ)
11 พฤษภาคม 2015
แบคทีเรียกลุ่มโคลิฟอร์ม (Coliform bacteria) คือกลุ่มของแบคทีเรียแกรมลบ (Gram negative bacteria) รูปร่างเป็นท่อน ไม่สร้างสปอร์ (Non spore forming) มีทั้งที่เคลื่อนที่ได้หรือเคลื่อนที่ไม่ได้ (Motile or non-motile bacteria) เป็นแบคทีเรียที่เจริญได้ทั้งมีอากาศและไม่มีอากาศ (Facultative anaerobe)
โคลิฟอร์มสามารถพบได้ในสภาพแวดล้อมที่เกี่ยวกับน้ำ (Aquatic environment) ทั้งในดินและพืช และมักพบประจำในทางเดินอาหารและอุจจาระของมนุษย์หรือสัตว์เลือดอุ่น โคลิฟอร์มสามารถแพร่ขยายและตายได้อย่างรวดเร็ว ทั้งนี้ขึ้นอยู่กับอุณหภูมิของน้ำและปัจจัยอื่นๆ
โคลิฟอร์มสามารถหมักน้ำตาลแล็กโทส (Lactose) ให้เกิดกรด และแก๊สได้ที่อุณหภูมิ 35-37 องศาเซลเซียส ภายใน 48 ชั่วโมง ไม่ทนความร้อน สามารถทำลายได้ง่ายด้วยความร้อนระดับการพาสเจอไรซ์ (Pasteurization) ไม่ผลิตเอนไซม์ออกซิเดส (Oxidase negative)
แม้ว่าตัวโคลิฟอร์มเองจะไม่ได้เป็นสาเหตุให้เกิดโรคร้ายแรง แต่ก็เป็นตัวชี้วัดได้ว่าอาจมีจุลินทรีย์ที่ทำให้เกิดโรคภัยไข้เจ็บ (Pathogenic organisms) อื่นอยู่ก็ได้ เช่น เชื้อแบคทีเรีย เชื้อไวรัส หรือ โปรตัวซัว (Protozoa) และปรสิตที่มีหลายเซลล์ (Multicellular parasites) โดยเชื้ออีโคไล (Escherichia coli = E. coli) ก็เป็นหนึ่งในแบคทีเรียกลุ่มโคลิฟอร์ม
อาการที่เกิดจากการติดเชื้อโดยทั่วไป มักจะมีผลกระทบต่อทางเดินอาหารและมีอาการคล้ายไข้หวัดใหญ่ เช่น เป็นไข้ ปวดท้อง และท้องเสีย อาการมักเกิดในเด็กและผู้สูงอายุ
และเนื่องจากโคลิฟอร์มนั้นอยู่ในน้ำได้นานกว่าจุลินทรีย์ชนิดอื่น ดังนั้นการไม่พบโคลิฟอร์มในน้ำก็น่าจะสันนิษฐานได้ว่าน้ำนั้นปลอดภัยที่จะดื่ม ตรงกันข้ามหากพบโคลิฟอร์มในน้ำ ก็หมายความว่าโอกาสที่จะป่วยจากการมีน้ำเป็นสาเหตุนั้นมีสูงขึ้น ด้วยเหตุนี้ เราจึงสามารถใช้ โคลิฟอร์มเป็นตัวชี้วัดความสะอาด (Indicator organisms) ของอาหารและน้ำได้
การที่ฝนตกและหิมะละลายก็สามารถทำให้โคลิฟอร์มปะปนเข้าสู่น้ำในทะเลสาบ สระน้ำ และแม่น้ำ ดังนั้นจึงควรนำน้ำจากบ่อมาทำการทดสอบน้ำว่ามีแบคทีเรียหรือไม่อย่างน้อยปีละครั้ง เพื่อให้มั่นใจว่าน้ำที่ใช้อยู่มีคุณภาพดี และควรทำการตรวจปรับปรุงระบบน้ำให้ดีอยู่เสมอ
นอกจากนี้ เครื่องทำความสะอาดน้ำที่ไม่ได้รับการดูแลรักษาก็สามารถเป็นแหล่งแพร่เชื้อได้ จึงควรมีการเปลี่ยนไส้กรองน้ำหรือทำความสะอาดเครื่องตามระยะเวลาที่กำหนดไว้
ทั้งนี้ มีคำแนะนำการป้องกันการติดเชื้อโคลิฟอร์มในน้ำและอาหารดังนี้
- ควรต้มน้ำก่อนใช้บริโภค
- หุงต้มอาหารให้ร้อนระดับการพาสเจอไรซ์ (Pasturization)
- เก็บอาหารที่ทำให้สุกแล้วที่อุณหภูมิต่ำ หากนำมารับประทานต้องอุ่นให้เดือดก่อน
- ป้องกันการปนเปื้อนข้าม (Cross contamination) โดยเฉพาะอาหารที่ปรุงสุกและอาหารพร้อมรับประทานกับอาหารดิบ ด้วยการแยกเก็บ
- ควบคุมให้พนักงานหรือบุคคลที่สัมผัสกับอาหารปฏิบัติตามสุขอนามัยที่ดี
แหล่งข้อมูล
- Coliform bacteria. [2015, May 10].
- Coliform Bacteria in Drinking Water Supplies. [2015, May 10].
- Coliform Bacteria. [2015, May 10].